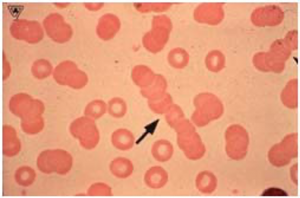

Alkaline ionized water is used for drinking and cooking, and provides users with several important health benefits:
- ALKALIZING: Restores pH balance by reducing acidity levels in the body
- ANTIOXIDANT: Helps to neutralize free radicals that can cause cellular and DNA damage
- SUPER-HYDRATING: Smaller water cluster size allows water to penetrate cells more easily
- MINERAL RICH: Contains higher concentrations of alkaline minerals such as Calcium, Magnesium, and Potassium which are vital to human health
- OXYGEN RICH: increases the amount of dissolved oxygen in the blood
- DETOXIFYING: eliminates mucus build-up on colon walls, thus improving the body’s ability to absorb important nutrients
- CLEANSING: contributes to flushing out acidic waste and toxins that have accumulated in the body over time
- ENERGIZING: negatively charged hydroxyl ions contribute to increased energy, mental clarity, and overall alertness
- WEIGHT CONTROL: reduces the body’s need for fatty tissues which protect vital organs from acidity by storing acidic waste in less critical parts of the body
- CLEAN WATER: pre-filtration cartridge inside the ionizer removes chlorine and other common pollutants present in tap water
- REMOVES PESTICIDES: strong alkaline water with a pH over 10.5 helps to remove pesticides from fresh fruits and vegetable
The importance of pH balance
Are you too acidic?

Mild acidosis can lead to such problems as:
- Weight gain, obesity and diabetes
- Joint inflammation, arthritis
- Bladder conditions, kidney stones
- Cardiovascular diseases
- Immune deficiency
- Cancer, chronic illness
- Osteoporosis
- Hormone concerns
- Premature aging
- Acceleration of free radical damage
- Low energy and chronic fatigue
- Slow digestion and elimination
- Yeast and fungal overgrowth
What makes us acidic?
- WHAT WE EAT including meat, fish, poultry, dairy, grains, refined or processed foods, fast food
- WHAT WE DRINK including coffee, soft drinks, alcohol, many types of water (distilled, bottled…)
- WHAT WE THINK including stress, worries, anxiety, negative thoughts
- POLLUTION AND TOXINS that are omnipresent in the world we live in
- INTENSE PHYSICAL EXERCISE that produces lactic acid
- DEHYDRATION which slows down the body’s ability to cleanse itself through the kidneys
- TOBACCO & DRUG USE
Alkaline neutralizes acid
Drinking alkaline ionized water on a daily basis helps neutralize acid to maintain or restore the body’s optimal pH balance. When our body is in equilibrium, our multiple self-regulating control mechanisms are able to operate in ideal conditions to efficiently deliver nutrients to our cells and to dissolve and eliminate waste products through the body’s natural elimination channels.
Understanding pH balance
The human body is designed to maintain a very delicate pH balance in its fluids, tissues and systems. As most biochemical reactions essential to life take place in an aqueous environment, however, it is our blood plasma and interstitial fluids surrounding the cells that are most sensitive to acid-alkaline imbalance. When these fluids are maintained within a narrow pH range of 7.35 to 7.45, our body’s immune system is operating in optimal conditions and is able to fight off illness and disease. Over acidification of the body, on the other hand, is a dangerous condition that weakens all body systems, and can give rise to an internal environment conducive to disease and even death.
Luckily, however, our body has several self-regulating control mechanisms – also called homeostatic systems – that protect us from wide fluctuations in our blood’s pH levels.
BICARBONATE BUFFERS
One of the most important buffer agents in humans is bicarbonate. When carbon dioxide (CO2) mixes with water (H2O), carbonic acid is formed (H2CO3). When carbonic acid dissociates in an aqueous environment, it releases a molecule called a bicarbonate ion (HCO3–). Bicarbonate ions act as buffers because they bond with positively charged alkaline ions such as calcium, sodium, potassium and magnesium ions and help the body neutralize an increase in the blood’s acidity levels.
One of the body’s pH control mechanisms is called the acid-base buffer system. Buffers are substances which are capable of stabilizing pH in an aqueous solution. Alkaline (base) buffers are released into the blood stream when the blood becomes too acidic, and conversely, acidic buffers come into play if the blood pH becomes too alkaline.
Unfortunately, however, our Western diet and fast-paced lifestyle put a heavy acidic burden on our body and the blood’s buffer system can’t always keep up. This leads to the gradual acidification of our blood and the body will then turn to other mechanisms to try and protect itself. However, these alternate mechanisms can sometimes trigger other types of problems that can lead to weight gain, premature aging, and the onset of multiple diseases.
Accumulation of metabolic waste
Every living cell within our body creates waste products. The nutrients from our food are delivered to each cell and they burn with oxygen to provide energy for us to live. The burned nutrients are the waste products. These waste products, which are mostly acidic, are discharged from our body through our various elimination channels. That explains why urine and perspiration are acidic.
The problem, however, is that if our internal environment is not maintained in a state of pH balance, our body’s ability to eliminate the waste products slows down. To protect itself, the body converts acidic waste into solid waste and stores it in less critical areas of the body. The accumulation of solid waste can contribute to many health problems including excess weight, clogged arteries, arthritis, kidney stones, and various other chronic illnesses.
Calcium depletion
Calcium is absolutely essential to everyday health. Not only is it important in bone strength, but it plays an important role in blood pressure control, nerve function, and blood clotting. When the blood starts to become too acidic and the supply of alkaline buffers in the blood is insufficient to neutralize this acidity, however, the blood automatically seeks out other ways to reach pH balance. Since calcium is a very alkalizing mineral, the body will start drawing calcium from the bones and teeth in an effort to balance the blood’s pH levels.
As the body’s acidity increases, more and more calcium is removed from the bones. If left unchecked over a long period of time, this situation can lead to a loss of bone density which eventually leads to osteoporosis.
Stacked blood cells (Rouleau)
Red blood cells deliver oxygen, amino acids, electrolytes and vitamins to the cells and tissues in your body, and collect carbon dioxide and toxins for elimination. Healthy red blood cells are surrounded by a negative charge so they are continuously repelling one another as they race through our circulatory system. This allows them to efficiently release nutrients and absorb waste products. However, when your blood becomes more acidic, the red blood cells lose their negative charge and start to stick together, a process called ‘rouleau’ formation. When this happens, the blood cell’s exchange surface area is reduced and the transfer rate of the blood slows down. As such, the body’s ability to regenerate is compromised.
Micro-clustered water
Alkaline water super-hydrates the body

Water molecules come in clusters rather than single molecules. Tap water which is under pressure has very large clusters of 12-14 molecules. The ionization process breaks the electrical bonding of water molecules and restructures the water down to about 5-6 molecules per cluster. This smaller cluster size means that the water can be more easily absorbed into the cells, thereby providing superior hydration for the body and helping to dissolve and flush out acidic solid waste and toxins that have accumulated in the body.
The importance of good hydration
Since our bodies are made up of 60% water, the quality and quantity of water we consume will have a very dramatic impact on our overall state of health. Every healing and life giving process that happens in our body happens through water!
Yet many people do not hydrate themselves enough, or choose to drink coffee, tea, fruit juices, soft drinks, power drinks, and alcohol instead of water. The fact is that these beverages contain acid-forming substances which reduce our ability to absorb and retain water. In the case of alcohol and caffeinated drinks, these actively stimulate the kidneys to produce more urine, causing further water-loss.
You’re thirsty!

Water is without doubt THE most important nutrient available to us, yet it is also the one that is most frequently overlooked. Although deficiencies of other nutrients can be sustained for months or even years, a person can only survive a few days without water. Indeed, scientists rank water second only to oxygen as essential for life.
Approximately 60% of our total body weight and 80% of our brain is made up of water. Water plays a vital role in all bodily functions and is the main component of all the blood that travels through your body, carrying oxygen to your cells, muscles and organs. Water is a universal medium for biochemical reactions, joint lubrication, nutrient delivery, waste disposal, heat dispersion and temperature regulation.
Yet, many people are so dehydrated that they become sick. In his book, Your Body’s Many Cries for Water, Dr. F. Batmanghelidj reports how many diseases can be attributed to chronic dehydration and how drinking sufficient amounts of water, our most important nutrient, can resolve many of these health concerns.
When we don’t drink enough water, our bodily processes slow down, electrolytes and other nutrients can’t be transported properly, cell function reduces, heat-loss becomes difficult, and waste products and toxins are not efficiently eliminated through the kidneys and build up in our body over time.
Health Benefits of Ionized Water
Alkaline ionized water contributes to improved health and wellbeing
Water ionizers have been used in Japan and other parts of Asia for over 40 years and are certified by the Korean and Japanese Ministries of Health as an approved medical device.

Ionized water has helped millions of people fight disease, including arthritis, digestive problems, inflammatory conditions, skin disorders, weight problems, diabetes, cancer, acid reflux, gout, fatigue, allergies, and chronic pain.
Alkaline water has many health benefits. Most importantly alkaline water:
- Restores the body’s pH balance
- Acts as a powerful antioxidant
- Improves cellular hydration

Alkaline water restores the body’s pH balance
Do you often feel tired or lethargic? Do you suffer from frequent colds, infections, illnesses, or joint pain? Do your nails, skin, and hair look and feel unhealthy? If so, then your body may be too acidic!
Use this checklist to see how acidic your body may be
What you eat, drink, put on your skin, the quality of the air you breathe, the exercise you do and even the thoughts you think can all contribute to make your body acidic. Most people are too acidic, and that drains their energy and causes illness and disease without them realising that’s the cause.
Alkaline water acts as a powerful antioxidant

Alkaline ionized water is a strong source of anti-oxidants since it contains an abundance of free electrons which can be donated to the body in order to neutralize free radicals.
But what exactly is oxidation? Think of what happens to a slice of apple left out on the counter for a few hours: it turns brown due to exposure to unstable oxygen molecules in the air. Inside our bodies, our cells are also continuously subjected to oxidation due to the presence of oxygen free radicals, which are unstable molecules desperately seeking electrons for stability. Free radicals have been scientifically proven to cause cellular and DNA damage that contribute to aging and can lead to the onset of various diseases.
